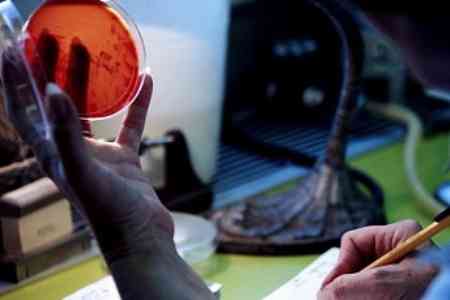
На поддержание армянского ЗАО "Центр производства изотопов" будет направлено 74,9 млн драмов

АрмИнфо. На поддержание армянского ЗАО "Центр производства изотопов" будет направлено 74,9 млн драмов. Правительство Армении на заседании 23 апреля перераспределило соответствующие объемы финансовых ресурсов.
По словам министра территориального управления и инфраструктур РА Сурена Папикяна, средства будут направлены Комитету по управлению государственным имуществом для поддержания площадей центра, дорогостоящего оборудования и материалов, систем кондиционирования и фильтрации, а также на переподготовку специалистов, занятых в работах по запуску предприятия. Министр отметил, что Центр в настоящее время не осуществляет какой-либо деятельности, но фактически находится в состоянии запуска. Он включен в перечень объектов государственного имущества, подлежащего приватизации, согласно государственной программе на 2017-2020г.г. Папикян констатировал, что центр обладает и лабораторией по производству лекарств. В свою очередь, министр здравоохранения РА Арсен Торосян сообщил, что если бы не COVID-19, центр уже принимал бы пациентов. В 2020 году центр не финансировался, и Министерство вынуждено было привлекать средства с других ЗАО, чтобы работа в центре не прекращалась. Осталось решить две небольшие проблемы - доставить из Бельгии несколько материалов, которые по своим характеристикам относятся к категории опасных. Изучаются различные варианты их транспортировки в Армению, в том числе, с использованием территории Германии. Кроме того, необходимо провести с зарубежными партнерами оценку состояния лабораторий. Однако по причине коронавируса и закрытых границ осуществить данные мероприятия будет достаточно сложно. По всей видимости, оценку лабораторий придется провести в дистанционном режиме. Торосян указал на важность центра, поскольку закрытые границы не позволяют гражданам Армении, страдающих онкологическими заболеваниями, выезжать на обследование в Грузию или в Россию. Министр выразил надежду, что Центр останется в собственности государства, и в этом случае Министерство здравоохранения готово принять его на свой баланс. Он заметил, что вместе с Национальным центром онкологии Центр производства радиоизотопов может стать единым конгломератом.
Между тем, как заметил вице-премьер Тигран Авинян, вопрос с задействованием центра увязывается с арбитражными разбирательствами.
Проблема связана с нарушениями положений договора с лицом, ранее управлявшим центром. Но процесс задействования, как заметил вице-премьер, продолжается.
Отметим, что ранее правительственным решением был ликвидирован Центр лучевой терапии. Строительство центра началось параллельно со строительством центра радиоизотопов, которые призваны были стать базовыми структурами Центра превосходства в области онкологии. Решение о строительстве Центра превосходства было принято правительством РА в октябре 2010 года. Проект реализовывался на кредитные средства Всемирного банка. На реализацию программы было инвестировано 2,2 млрд драмов бюджетных средств и $4 млн кредитных ресурсов, из которых погашено ровно $2 млн. Работы выполнены на 95%. Проект предусматривалось реализовать в три этапа, в рамках которых планировалось наладить производства радиоизотопов и создать Центр молекулярной профилактики, после чего планировалось создать Центр по предоставлению амбулаторных услуг в области лучевой терапии, а также (при наличии частного инвестора) хирургического и химиотерапевтического центра. Первый этап программы по производству радиоизотопов уже завершен. Предусматривалось, что Центр будет обслуживать минимум 1000 пациентов, еще около 400 пациентов смогут проходить брахитерапию, столько же человек - диагностику. Центр создавался по инициативе Национального фонда конкурентоспособности Армении в рамках Меморандума о взаимопонимании, подписанного между Фондом и бельгийской компании Global Medical Solutions. Он получил оборудование на сумму в 2.5 млн. евро, а также техническое содействие в рамках сотрудничества с бельгийской компанией IBA.
Согласно статистическим данным, ежегодно в Армении 2700 людей становятся инвалидами в результате онкозаболеваний, из-за чего экономика несет убытки, превышающие 75 млн. драмов ежегодно. На диспансерном лечении в Армении находятся около 32 тысяч онкологических больных.